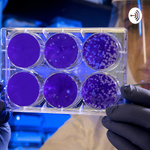

Mpoukitses Biologias
Εδώ θα βρεις ηχητικά αρχεία για
το μάθημα της Βιολογίας Λυκείου. Τα βασικά σημεία της θεωρίας χωρισμένη σε μικρές ενότητες.. Μπουκίτσες βιολογίας…
© Maria-Eleni Exadaktylou · more info
Artwork and data is from the podcast’s open RSS feed; we link directly to audio · Read our DMCA procedureThis podcast may use dynamic content insertion
Stats: Statistics are produced by Spotify for Creators to help Mpoukitses Biologias to understand how many downloads it is getting, or how many people are listening. Your device’s IP address and user agent is used to help calculate this figure. Spotify for Creators is IAB v2 certified. Here is more detail about podcast statistics.
Dynamic content insertion: Spotify for Creators may use limited data that they know about you - the device you’re using, the approximate location you’re in, or other data that can be derived from this, like the current weather forecast for your area - to change parts of the audio. Mpoukitses Biologias may do this for advertising or for other forms of content, like news stories.
Mpoukitses Biologias is able to use the above tools since its podcast host or measurement company offers this service. It doesn’t mean that this individual podcast uses them, or has access to this functionality. We use open data.
Listen and follow
Information for podcasters
- Podcast GUID:
9ff5ef8d-8eee-553b-823b-4f4f0ba64c63 - This podcast doesn’t have a trailer. Apple Podcasts has a specific episode type for a trailer, which also gets used by many other podcast apps: but there isn’t one correctly marked in the RSS feed from Spotify for Creators.
- This podcast appears to be missing from Luminary and iHeartRadio. We list all the podcast directories to be in.
- See this podcast’s listener numbers, contact details and more at Rephonic
- Validate this podcast’s RSS feed with Livewire, Truefans or CastFeedValidator